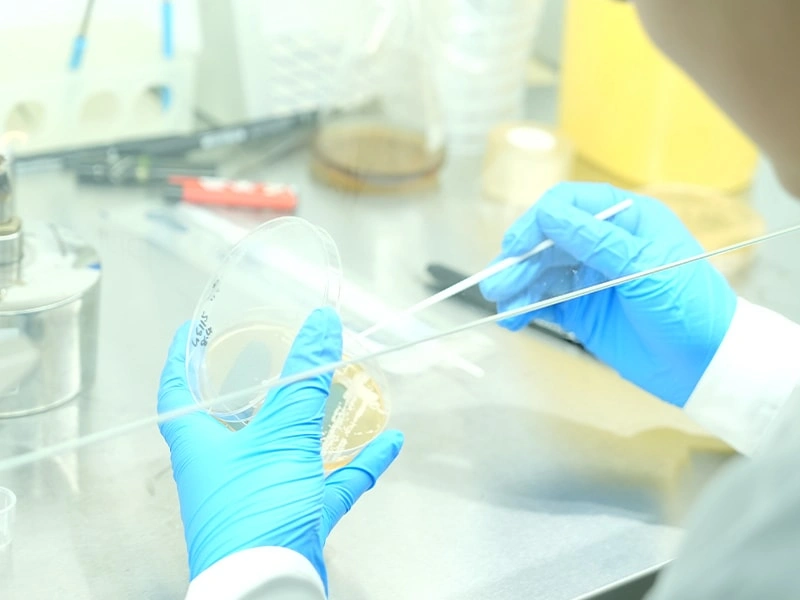
High-Throughput Screening Platform

R&D LABORATORY
High-Throughput Screening Platform
Integrated application of molecular biology, cell biology, computer science, and automation control technologies enables miniaturized, automated, and scalable substance testing, achieving rapid and high efficiency screening objectives.